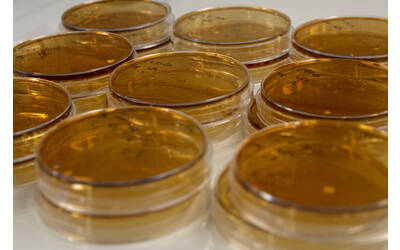

Descrizione
I servizi riguardano:
- analisi microbiologiche secondo i metodi ufficiali OIV, IFU e ISO applicati al settore agroalimentare, in particolare enologico e caseario
- analisi microbiologiche su materie prime quali uve, mosti, latte e derivati, vegetali per determinarne l’attitudine alla trasformazione e i rischi microbiologici associati
- controlli su starter microbici, lieviti secchi attivi e colture batteriche liofilizzate
- selezione, conservazione e riproduzione di starter di fermentazione specifici di aziende agroalimentari o areali produttivi.
- monitoraggio e prevenzione delle contaminazioni microbiche durante i processi di produzione alimentare, potenzialmente condotti anche senza l’ausilio di starter
- ottimizzazione dei processi di sanificazione e implementazione di tecnologie per la riduzione del rischio di alterazioni microbiologiche
- controllo microbiologico su alimenti per verificarne la durabilità, la conformità a capitolati tecnici, il rischio di alterazioni microbiologiche.